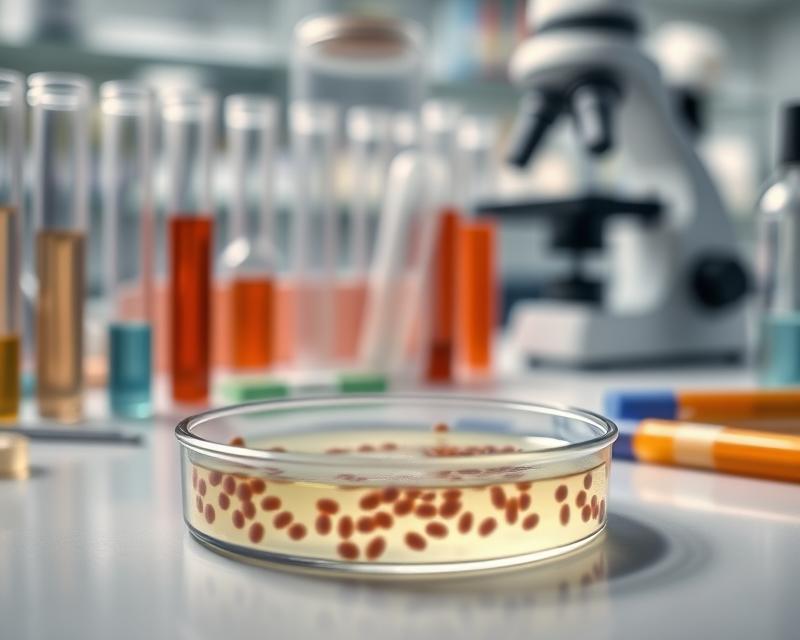

Zakażenia układu moczowego to powszechny problem zdrowotny, który dotyka wiele osób, niezależnie od wieku czy płci. Jednym z kluczowych narzędzi w diagnostyce tych infekcji jest posiew moczu, który pozwala na identyfikację patogenów oraz ocenę ich wrażliwości na antybiotyki. Badanie to nie tylko potwierdza obecność bakterii, ale również stanowi fundament skutecznej terapii. Warto zrozumieć, jakie bakterie najczęściej wywołują te infekcje oraz jakie objawy powinny nas skłonić do wykonania takiego badania. Dzięki odpowiedniej diagnostyce i zrozumieniu procesu, możemy skuteczniej walczyć z infekcjami i poprawić jakość naszego życia.
Co to jest posiew moczu i jakie ma znaczenie w diagnostyce zakażeń układu moczowego?
Posiew moczu to istotne badanie, które pozwala zidentyfikować patogeny obecne w moczu oraz diagnozować infekcje układu moczowego (ZUM). Głównym jego celem jest wykrycie konkretnych bakterii, grzybów i wirusów, co jest kluczowe dla skutecznego leczenia. Badanie ocenia zarówno ilość, jak i jakość mikroorganizmów w moczu oraz ich wrażliwość na antybiotyki, co bezpośrednio wpływa na wybór najbardziej efektywnej terapii.
Posiew moczu wykonuje się w przypadku:
- podejrzenia zakażenia dróg moczowych,
- nawracających infekcji,
- specjalnych grup pacjentów z innymi schorzeniami.
Dzięki identyfikacji patogenów, lekarz może:
- potwierdzić obecność zakażenia,
- ustalić jego źródło,
- ocenić ewentualną oporność na antybiotyki.
Taki krok jest niezwykle ważny dla właściwego dobrania leczenia oraz zapobiegania rozwojowi oporności. Badanie to ma szczególne znaczenie dla:
- osób z powracającymi infekcjami,
- kobiet w ciąży,
- pacjentów z innymi schorzeniami.
W tych sytuacjach precyzyjne określenie czynników wywołujących infekcje jest kluczowe dla zdrowia i skuteczności leczenia. Hodowla mikroorganizmów w laboratoriach stanowi ważny element diagnostyki, co prowadzi do lepszej opieki medycznej. Regularne wykonywanie posiewów może również pomóc w monitorowaniu skuteczności terapii i dostosowywaniu leczenia w razie potrzeby.
Jakie bakterie i patogeny najczęściej powodują zakażenia układu moczowego?
Zakażenia układu moczowego najczęściej wynikają z obecności bakterii, a za 90% przypadków odpowiada Escherichia coli. Problemy zaczynają się, gdy mikroorganizmy przemieszczają się z odbytu przez cewkę moczową do pęcherza.
Inne bakterie, takie jak Klebsiella czy Staphylococcus saprophyticus, także mogą wywoływać te infekcje. Staphylococcus saprophyticus występuje szczególnie u młodych kobiet, co może mieć związek z różnymi czynnikami hormonalnymi oraz anatomicznymi.
Zakażenia układu moczowego dzielą się na:
- niepowikłane,
- powikłane.
Ważne czynniki wpływające na formę zakażeń to:
- kamienie nerkowe,
- schorzenia prostaty.
Dlatego wczesne rozpoznanie i właściwe leczenie są niezbędne, aby uniknąć powikłań oraz zminimalizować objawy, takie jak:
- ból podczas oddawania moczu,
- zmiana koloru moczu.
Zwracanie uwagi na te sygnały jest istotne, by nie dopuścić do pogorszenia zdrowia.
Co oznaczają bakteriomocz i kolonizacja drobnoustrojów?
Bakteriomocz to stan, w którym w moczu stwierdza się obecność bakterii. Zwykle jest to symptom zakażenia układu moczowego. Gdy w moczu znajdowane są patogeny, posiew moczu staje się kluczowym badaniem, umożliwiającym identyfikację tych mikroorganizmów. Wiedza na temat rodzaju obecnych bakterii ma ogromny wpływ na dalszy proces diagnostyczny oraz planowanie leczenia. Objawy bakteriomoczu mogą być różne – od łagodnych infekcji, aż po poważniejsze stany zapalne, w zależności od gatunku i liczby bakterii.
Kolonizacja drobnoustrojów oznacza, że bakterie zasiedlają drogi moczowe, lecz nie wywołują typowych objawów infekcji. Taki stan może występować u zdrowych osób, a sama obecność bakterii nie zawsze wymaga interwencji medycznej. Kluczową różnicą pomiędzy bakteriomoczem a kolonizacją jest to, że w przypadku bakteriomoczu często obserwuje się zmiany w wynikach analiz moczu oraz występowanie objawów klinicznych.
Zrozumienie tych pojęć jest niezwykle ważne dla diagnozowania zakażeń układu moczowego. Pomaga to w skuteczniejszym dobraniu terapii oraz monitorowaniu stanu zdrowia pacjentów. W diagnostyce obecność bakterii lub ich kolonizacja wpływa nie tylko na wyniki badań, ale również na podejmowane decyzje dotyczące leczenia i dalszych diagnostyk. Należy pamiętać, że nie każdy przypadek bakteriomoczu wymaga natychmiastowej terapii; w niektórych sytuacjach wystarczająca może być jedynie obserwacja i dodatkowe badania.
Jakie objawy kliniczne sugerują infekcję układu moczowego?
Objawy kliniczne związane z infekcją układu moczowego są istotnym elementem procesu diagnostycznego. Najczęściej występujące objawy to:
- ból towarzyszący oddawaniu moczu,
- uczucie nagłego parcia na pęcherz,
- pieczenie przy mikcji.
Zmiany w kolorze moczu, takie jak mętność czy obecność krwi, mogą także wskazywać na wystąpienie infekcji.
Inny niepokojący objaw to ból w podbrzuszu oraz w okolicy lędźwiowej, który również może sugerować zakażenie układu moczowego. Kiedy pojawiają się takie symptomy, lekarz może zlecić wykonanie posiewu moczu, co jest kluczowe dla potwierdzenia diagnozy i dobrania odpowiedniej terapii.
Szybka reakcja na te objawy jest istotna, aby zapobiec rozwojowi poważniejszych problemów zdrowotnych. Należy także pamiętać o intensywności symptomów – im silniejsze objawy, tym wyższy priorytet w skonsultowaniu się z lekarzem.
Jakie preparaty i metody stosuje się w badaniu moczu w diagnostyce mikrobiologicznej?
W diagnostyce mikrobiologicznej moczu niezwykle istotne jest wykorzystanie właściwych preparatów i metod. Dzięki nim możemy przeprowadzić szczegółowe analizy próbki.
Najczęściej używane są:
- pożywki hodowlane,
- które wspierają rozwój drobnoustrojów,
- takich jak bakterie czy grzyby.
Te preparaty są kluczowe w testach mikrobiologicznych, które pozwalają ustalić przyczynę zakażeń układu moczowego.
Sposób pobierania moczu, szczególnie technika uzyskiwania środkowego strumienia, odgrywa istotną rolę w uzyskaniu wiarygodnych wyników. Starannie wykonane pobranie próbki minimalizuje ryzyko zanieczyszczenia, które mogłoby prowadzić do mylnych interpretacji w diagnostyce. Dlatego tak ważne jest, aby zwracać uwagę na przyjęte techniki, aby zredukować błędy.
Dodatkowo, przeprowadza się antybiogram, który określa wrażliwość wykrytych bakterii na różne antybiotyki. To cenne narzędzie w terapii infekcji układu moczowego, umożliwiające wybór odpowiedniego leczenia.
Gdy odpowiadamy na obecność konkretnych patogenów i ich reakcję na leki, diagnostyka mikrobiologiczna moczu staje się kluczowym elementem skutecznego leczenia oraz monitorowania zakażeń. Regularne korzystanie z tych metod i preparatów jest niezbędne w codziennej praktyce klinicznej.
Jak prawidłowo pobrać i transportować próbkę moczu do posiewu?
Aby prawidłowo pobrać i przetransportować próbkę moczu do posiewu, warto przestrzegać kilku kluczowych zasad.
- Użyj jałowego pojemnika,
- zbieraj mocz rano, zwłaszcza ze środkowego strumienia,
- oddaj niewielką ilość moczu do toalety,
- pobierz mocz do jałowego pojemnika z środkowej części strumienia,
- końcową porcję oddaj do toalety.
Zanim przystąpisz do pobierania próbki, pamiętaj o zachowaniu odpowiedniej higieny. Dokładnie umyj ręce oraz okolice intymne wodą z mydłem lub płynem do higieny intymnej, a następnie osusz je papierowym ręcznikiem. Lepiej unikać stosowania środków antybakteryjnych, ponieważ mogą one wpłynąć na wyniki badania. Zadbaj o to, aby pojemnik był nowy i fabrycznie zamknięty, co pomoże zminimalizować kontakt wewnętrznych powierzchni.
Po pobraniu próbki, dostarcz mocz do laboratorium jak najszybciej. Dzięki temu zmniejszysz ryzyko zanieczyszczania oraz zwiększysz wiarygodność wyników. W przypadku, gdy nie możesz od razu transportować próbki, przechowuj ją w lodówce w temperaturze około 4°C, jednak nie dłużej niż przez kilka godzin, zazwyczaj do 24 godzin.
Oto kluczowe wskazówki dotyczące przechowywania próbki moczu;
| wytyczna | zalecenie |
|---|---|
| transport | jak najszybciej |
| temperatura | około 4°C |
| czas przechowywania | do 24 godzin |
Ważne jest, aby próbka była szczelnie zamknięta, co zapobiegnie wyciekowi lub kontaminacji podczas transportu. W moim doświadczeniu, szybkie dostarczenie próbki do laboratorium ma istotny wpływ na jakość uzyskiwanych wyników.
Co to jest jałowy pojemnik i jakie ma znaczenie w badaniu moczu?
Jałowy pojemnik to sterylny zbiornik, wykorzystywany do pobierania próbek moczu. Jego znaczenie w diagnostyce jest ogromne, ponieważ umożliwia przeprowadzenie dokładnych badań. Głównym celem jego stosowania jest zapobieganie zanieczyszczeniu próbki bakteriami pochodzącymi z cewki moczowej. Korzystając z jałowego pojemnika, mamy pewność, że próbka pochodzi jedynie od pacjenta, co jest niezbędne dla uzyskania precyzyjnych i wiarygodnych wyników.
Należy jednak pamiętać, że kontakt z zanieczyszczeniami może prowadzić do fałszywych diagnoz. Takie sytuacje mogą znacznie opóźniać wprowadzenie skutecznego leczenia. Dlatego tak ważne jest przestrzeganie zasad zbierania próbek oraz używanie jałowych pojemników, gdyż to klucz do prawidłowej diagnostyki.
Właściwe przygotowanie pacjenta ma kluczowe znaczenie.
- pacjent powinien dokładnie umyć ręce,
- powinien również zadbać o higienę okolic cewki moczowej,
- to znacząco ogranicza ryzyko zanieczyszczenia.
Dlaczego ważny jest mocz poranny i środkowy strumień moczu?
Poranny mocz oraz mocz pobrany ze środkowego strumienia odgrywają niezwykle istotną rolę w diagnozowaniu infekcji dróg moczowych. Wybór porannego moczu do badań jest uzasadniony, ponieważ cechuje się on wyższą koncentracją substancji, co sprzyja identyfikacji patogenów. Dzięki temu nawet niewielkie ilości bakterii można łatwiej wykryć podczas analizy.
Pobieranie moczu ze środkowego strumienia ma na celu ograniczenie ryzyka zanieczyszczenia próbki przez bakterie z cewki moczowej. Poprzez tę metodę uzyskujemy próbkę, która lepiej oddaje rzeczywisty stan zdrowia pacjenta, co z kolei obniża prawdopodobieństwo pojawienia się fałszywych wyników mogących prowadzić do błędnej diagnozy.
Aby uzyskać wiarygodne wyniki posiewu moczu, kluczowe jest odpowiednie przygotowanie do badania oraz właściwa technika pobrania próbki. Z własnego doświadczenia mogę stwierdzić, że korzystanie z moczu porannego i moczu ze środkowego strumienia jest standardową praktyką diagnostyczną. Ta metoda umożliwia efektywniejsze wykrywanie zakażeń i szybszą interwencję terapeutyczną.
Jakie są metody cewnikowania i ich wpływ na wyniki posiewu?
Cewnikowanie to istotna technika pobierania moczu, zwłaszcza gdy inne metody zawodzą. Najczęściej wykonuje się je przez cewkę moczową, jednak ta procedura może wpłynąć na wyniki posiewu. Istnieje bowiem ryzyko, że dodatkowe bakterie dostaną się do próbki. Dlatego kluczowe jest przestrzeganie zasad aseptyki, które przyczyniają się do uzyskania wiarygodnych wyników diagnostycznych.
Zanieczyszczenia mogą zafałszować wyniki posiewu i mogą pochodzić zarówno z cewnika, jak i z okolic intymnych pacjenta. Aby zminimalizować to ryzyko, personel medyczny powinien ściśle stosować się do procedur aseptycznych oraz technik cewnikowania. Przykłady takich działań obejmują:
- mycie rąk,
- zakładanie rękawiczek,
- korzystanie z jałowych pojemników do przechowywania próbki.
Nawet najmniejsze uchybienia w tych elementach mogą prowadzić do istotnych błędów w diagnozowaniu.
Prawidłowo przeprowadzone cewnikowanie pozwala na uzyskanie czystej próbki moczu, co jest niezbędne w diagnostyce zakażeń układu moczowego. Kiedy wyniki posiewu są rzetelne, lekarze mogą skuteczniej identyfikować patogeny powodujące infekcje i dobierać odpowiednie terapie. To ma ogromny wpływ na powodzenie leczenia pacjentów. Z mojego doświadczenia wynika, że dokładne przestrzeganie zasad aseptyki podczas cewnikowania wyraźnie podnosi jakość uzyskiwanych wyników.
Jakie są najczęstsze błędy i zanieczyszczenia próbki moczu?
W przypadku pobierania próbki moczu najczęstszymi problemami są:
- zanieczyszczenie bakteriami z cewki moczowej,
- niewłaściwe przygotowanie do badania.
Te trudności mogą prowadzić do fałszywie dodatnich wyników, co znacznie utrudnia postawienie trafnej diagnozy zakażeń układu moczowego.
Zanieczyszczenie próbki to poważna kwestia, ponieważ wpływa negatywnie na interpretację wyników, co z kolei ma wpływ na dobór dalszej terapii pacjenta. Aby ograniczyć ryzyko zanieczyszczenia, kluczowe jest przestrzeganie rygorystycznych zasad dotyczących zbierania próbek. Ważne, by pobierać je w odpowiednich warunkach, używając jałowych pojemników oraz stosując techniki ograniczające kontakt z bakteriami z zewnętrznych źródeł. Niezwykle istotne jest, aby pacjenci zdawali sobie sprawę z konieczności dokładnego umycia rąk przed pobraniem moczu.
Nieprzestrzeganie zasad przygotowania pacjenta może również negatywnie wpływać na jakość próbki, prowadząc do błędnych interpretacji wyników. Dlatego warto zadbać, aby pacjenci otrzymali jasne instrukcje dotyczące przygotowania się do badania moczu, ponieważ to kluczowy krok w kierunku uzyskania rzetelnych wyników diagnostycznych.
Jak wykrywać patogeny i oceniać wyniki badania moczu ilościowo i jakościowo?
Wykrywanie patogenów w moczu odgrywa kluczową rolę w diagnozowaniu infekcji układu moczowego. Proces ten polega na wykonaniu posiewu moczu, co pozwala na ocenę obecności bakterii zarówno pod kątem ilości, jak i jakości. Wyniki badań można określić jako dodatnie, co wskazuje na obecność patogenów, lub ujemne, co oznacza ich brak. Dodatni wynik sugeruje konieczność dalszych badań oraz działań terapeutycznych.
Oceny ilościowe wyrażane są w jednostkach CFU/ml, co oznacza liczbę kolonii na mililitr. Te informacje są niezbędne dla lekarzy, którzy mogą na ich podstawie oszacować, jak dużo bakterii znajduje się w próbce oraz jakie jest nasilenie zakażenia. Dzięki tym danym, specjaliści są w stanie skierować pacjenta na odpowiednią terapię. Ocena jakościowa z kolei polega na identyfikacji konkretnych patogenów, co pozwala na dokładniejszą diagnozę i skuteczniejsze leczenie. Każdy z patogenów wymaga bowiem innego podejścia terapeutycznego, co podkreśla wagę precyzyjnej identyfikacji.
Przykładem powszechnie wykrywanych patogenów w badaniach moczu są:
- E. coli,
- Klebsiella,
- Proteus,
- Staphylococcus saprophyticus.
Również kluczowe jest zrozumienie zarówno aspektów ilościowych, jak i jakościowych tych badań, co ma istotne znaczenie dla skuteczności terapii oraz monitorowania stanu zdrowia pacjenta. W praktyce, lekarze zwykle zaczynają od analizy ilościowej, aby ocenić nasilenie zakażenia, a następnie przechodzą do identyfikacji występujących patogenów. Takie podejście umożliwia precyzyjne dostosowanie leczenia do potrzeb pacjentów.
Jak interpretować wyniki ujemne i dodatnie posiewu moczu?
Wyniki posiewu moczu mogą być zarówno pozytywne, jak i negatywne, a ich znaczenie w diagnozowaniu oraz leczeniu infekcji układu moczowego jest niezwykle istotne. Pozytywny wynik wskazuje na obecność patogenów, co potwierdza wystąpienie infekcji. W takiej sytuacji lekarz zyskuje nie tylko nazwę zidentyfikowanego drobnoustroju, ale także wyniki antybiogramu, jeśli taki został przeprowadzony, co daje informację na temat wrażliwości na różne antybiotyki. Te dane są kluczowe dla skutecznego dostosowania leczenia do konkretnego patogenu.
W przypadku wyniku negatywnego, sugeruje on, że w moczu nie ma drobnoustrojów, co z reguły oznacza brak aktywnej infekcji bakteryjnej czy grzybiczej. Mimo to, warto pamiętać, że negatywny wynik nie zawsze wyklucza możliwość infekcji. W niektórych sytuacjach konieczne jest powtórzenie badania, zwłaszcza jeśli występują objawy kliniczne sugerujące inną możliwość.
Interpretacja takich wyników powinna uwzględniać stan zdrowia pacjenta, co może czasami wymagać dodatkowych testów, aby ustalić, czy terapia jest rzeczywiście potrzebna. Dlatego dokładna analiza zarówno pozytywnych, jak i negatywnych wyników posiewu moczu jest kluczowa dla efektywnego diagnozowania oraz leczenia infekcji układu moczowego.
Co to jest antybiogram i jakie ma znaczenie w terapii zakażeń układu moczowego?
Antybiogram to istotne badanie laboratoryjne, które ocenia, w jaki sposób różne drobnoustroje reagują na antybiotyki. Dzięki niemu możliwe jest dokładne dobieranie skutecznych leków, co ma ogromne znaczenie w walce z zakażeniami układu moczowego, zwłaszcza w dobie rosnącej lekooporności bakterii.
Przeprowadzenie antybiogramu jest niezbędne po wykonaniu posiewu moczu, który identyfikuje patogen wywołujący infekcję. Lekarze, analizując wyniki obu badań, mogą dostosować terapię do konkretnego szczepu bakterii, co sprawia, że leczenie staje się bardziej skuteczne. Takie podejście pomaga ograniczyć ryzyko nawrotów zakażeń oraz rozwijania się oporności na antybiotyki.
Antybiogram jest szczególnie cenny w przypadku:
- przewlekłych zakażeń,
- nawracających infekcji,
- trudnych do leczenia zakażeń układu moczowego.
W takich okolicznościach niewłaściwy wybór antybiotyku może prowadzić do poważnych problemów zdrowotnych. Z tego powodu warto zwracać uwagę na wyniki antybiogramu, aby uniknąć niepożądanych skutków.
W obliczu coraz bardziej złożonych infekcji, które wymagają precyzyjnego leczenia, antybiogram staje się kluczowym narzędziem w skutecznej terapii zakażeń układu moczowego.
Jakie są możliwe przyczyny lekooporności bakterii w zakażeniach układu moczowego?
Lekooporność bakterii w zakażeniach układu moczowego stanowi poważne wyzwanie zdrowotne, którego źródłem są różnorodne czynniki. Kluczowym z nich jest niewłaściwe stosowanie antybiotyków, które prowadzi do powstawania szczepów odpornych na leczenie. Często zdarza się, że leki te są przepisywane bez wcześniejszego przeprowadzenia antybiogramu, co skutkuje niewłaściwym doborem terapii.
Nawracające infekcje układu moczowego jeszcze bardziej komplikują sytuację, gdyż ich niedostateczne monitorowanie stwarza sprzyjające warunki do rozwoju opornych szczepów bakterii. Ponadto, niewłaściwe leczenie empiryczne, polegające na podawaniu antybiotyków, które są nieskuteczne wobec aktualnych patogenów, pogłębia istniejące problemy.
Aby skutecznie walczyć z lekoopornością, istotne jest stosowanie antybiotyków zgodnie z wynikami antybiogramu. Dzięki temu terapie mogą być dokładnie dostosowane do indywidualnych potrzeb pacjenta. Kluczowe jest także mądre zarządzanie środkami przeciwdrobnoustrojowymi oraz edukacja zarówno pacjentów, jak i personelu medycznego na temat zasad prawidłowego stosowania antybiotyków.
Jak wpływa kamica układu moczowego na ryzyko infekcji?
Kamica układu moczowego znacznie podnosi ryzyko wystąpienia infekcji. Kiedy kamienie blokują przepływ moczu, może dojść do jego zastoju. Taka sytuacja sprzyja uszkodzeniu błony śluzowej, a także umożliwia drobnoustrojom łatwiejsze zasiedlenie tych obszarów. Zranione tkanki stają się wówczas bardziej podatne na atak bakterii, co może prowadzić do zakażeń układu moczowego.
Osoby z kamicą muszą szczególnie uważać na oznaki infekcji, które mogą obejmować:
- ból przy oddawaniu moczu,
- częste potrzeby wizyt w toalecie,
- gorączkę,
- ból w okolicy lędźwiowej.
Ważne jest, aby regularnie obserwować swoje samopoczucie i nie unikać konsultacji z lekarzem. Dzięki temu można w porę zidentyfikować i skutecznie leczyć ewentualne zakażenia. Pamiętaj, że wczesna interwencja odgrywa kluczową rolę w zachowaniu zdrowia układu moczowego.
Jakie są opcje terapii empirycznej w zakażeniach układu moczowego?
Terapia empiryczna w zakażeniach układu moczowego opiera się na stosowaniu antybiotyków wybranych z uwagi na najczęściej występujące patogeny oraz ich znaną wrażliwość na różne leki. W sytuacji, gdy lekarze jeszcze nie dysponują wynikami posiewu moczu, stawiają na leki o szerokim spektrum działania, co pozwala na szybką i efektywną interwencję, zwłaszcza w przypadkach poważnych infekcji.
Podczas wyboru antybiotyków kierują się lokalnymi wytycznymi dotyczącymi oporności bakterii. Wśród możliwych opcji znajdują się:
- trimetoprim-sulfametoksazol,
- nitrofurantoina,
- flukonazol.
Ze względu na różnorodność patogenów odpowiedzialnych za zakażenia układu moczowego, kluczowe staje się monitorowanie efektywności terapii. To pozwala lekarzom na dostosowywanie leczenia w oparciu o wyniki posiewów moczu. Różne patogeny mogą mieć odmienną wrażliwość na leki, co wpływa na skuteczność terapii.
Gdy uzyskuje się wyniki posiewu, lekarz może precyzyjnie dostosować leczenie do konkretnego patogenu, co umożliwia bardziej celowane działanie. Takie podejście znacząco zmniejsza ryzyko nieuzasadnionego stosowania antybiotyków oraz pozwala lepiej kontrolować rozwój oporności bakterii, co jest istotne w terapii zakażeń układu moczowego. Należy również pamiętać, że skuteczność leczenia może się różnić w zależności od indywidualnych cech pacjenta oraz charakterystyki samego zakażenia.
Jak monitorować objawy infekcji podczas leczenia?
Monitorowanie symptomów infekcji podczas leczenia jest niezwykle istotne dla efektywnej terapii zakażeń układu moczowego. Kluczowe jest regularne ocenianie stanu pacjenta oraz uważna obserwacja oznak klinicznych. Wśród najpowszechniejszych objawów możemy wymienić:
- ból przy oddawaniu moczu,
- zmiany w zabarwieniu moczu,
- inne dolegliwości.
Pacjenci powinni nie tylko zwracać uwagę na wszelkie nowe symptomy, ale również informować lekarza o nasileniu tych już istniejących, co może sugerować konieczność wprowadzenia zmian w leczeniu.
Osoby z zakażeniem układu moczowego powinny szczególnie pilnować swojego samopoczucia. Wczesne wykrycie ewentualnych komplikacji umożliwia szybsze dostosowanie terapii i zwiększa szanse na pełne wyleczenie. Regularne monitorowanie powinno obejmować także analizę wyników badań laboratoryjnych, które mogą ukazać, jak organizm reaguje na leczenie. Należy zwracać uwagę na jakiekolwiek zmiany, ponieważ dostarczają one cennych wskazówek dotyczących skuteczności wdrożonej terapii.

Najnowsze komentarze